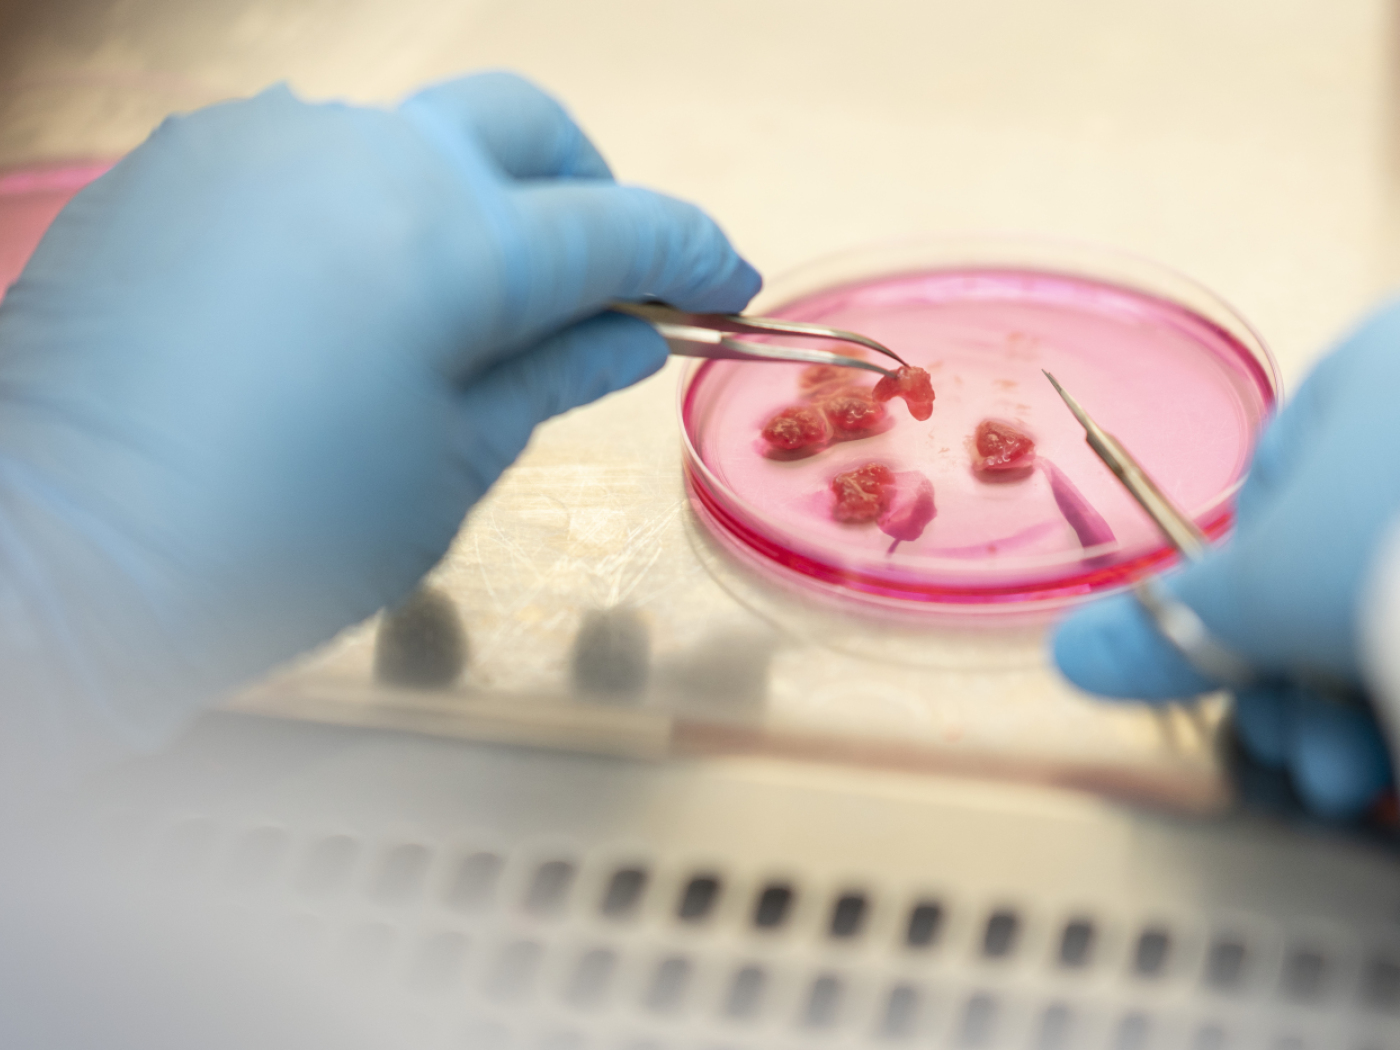
Synthetic meat: Israeli producer sets up shop in the canton of Zurich

River cleaned up in the National Park: 12,000 fish transferred
Keystone-SDA
Some 12,000 fish are being removed from the River Spöl in the Swiss National Park. This operation is necessary before cleaning up the riverbed, which was contaminated by PCBs during maintenance work in 2016.
The site for the remediation work is being set up at the foot of the Punt-dal-Gall dam wall, which holds back the waters of Lake Livigno, Giacum Krüger, Director of the Engadine electricity company EKW stated on Wednesday. At the beginning of 2026, the riverbed will be cleared of the carcinogenic polychlorinated biphenyls (PCBs) that pollute it.
+Get the most important news from Switzerland in your inbox
The contamination with PCBs, chemical substances formerly contained in paint, insulation materials and plastics, occurred nine years ago during maintenance work on the dam wall. Five kilometres of the river were polluted.
The river trout that live there are currently fished with nets, then transferred downstream by helicopter into special containers before being released back into the water. Around twenty people are involved in the operation.
“We lowered the level of the river to make it easier to capture them. Once the transfer is complete, we’ll empty the river of its water and start cleaning up the sediment,” said Krüger. Everything that has been contaminated will be taken to Aargau for burning. The decontamination of the river is due to be completed by the end of 2026.
“We hope that 90-95% of the PCBs can be extracted from the sediment, particularly the finest material,” says Ruedi Haller, Director of the National Park. The operation should help to restore the balance within the ecosystem.
Financial issue to be resolved later
This is a major human intervention in the 111-year history of Switzerland’s only National Park, but there have already been far greater ones. “In the 1960s, the construction of the dam was the subject of debate, and the Ofen Pass road passes through the park,” recalls Haller.
Similarly, the clean-up of the Spöl continues to be the subject of debate. It is still unclear who will foot the bill. “To speed up the work, we have decided to separate this project from the financial and liability issues of pollution,” Haller emphasised.
Adapted from French by DeepL/ac
We select the most relevant news for an international audience and use automatic translation tools to translate them into English. A journalist then reviews the translation for clarity and accuracy before publication.
Providing you with automatically translated news gives us the time to write more in-depth articles. The news stories we select have been written and carefully fact-checked by an external editorial team from news agencies such as Bloomberg or Keystone.
If you have any questions about how we work, write to us at english@swissinfo.ch